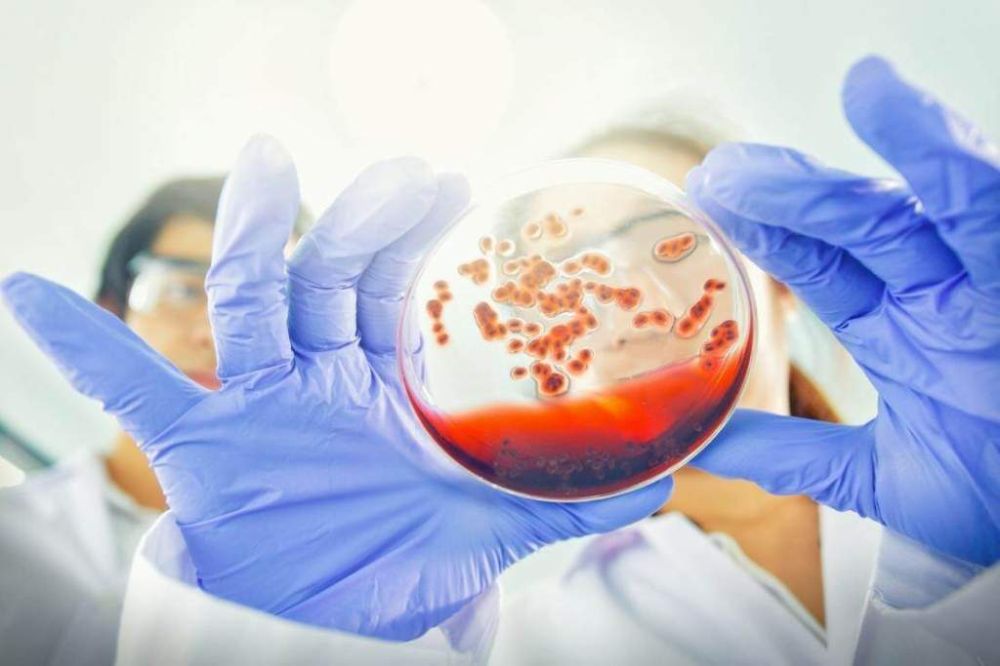
�������� �� ��� � ����������� �������������

Новости за 01.10.2024
Министр экономики Молдовы Думитру Алайба попал в секс скандал с проститутками.Как неудобно прямо перед президентскими выборами дискредитирует партию Майи Санду.
Более пятисот первокурсников Приднестровского госуниверситета сегодня стали частью студенческого братства. Они дали клятву не жалеть сил и времени на постижение наук.Некоторых первокурсников по итогам сентября уже наградили за активное участие в жизни...
Квадроберы вышли на новый уровень — в Омске женщина выгуливала своего ребенка на поводке. Рядом в это время резвилась настоящая собака.Маму с поводком в руках заметили недалеко от дома на Пригородной улице. Судя по видео, игра в собаку понравилась...
Похититель телефона задержан в Рыбнице Выпивший 43-летний рыбничанин украл телефон у цветочницы. Притворился, что хочет позвонить.Женщина вызвала милицию, и мужчину задержали с похищенным телефоном.МВД: Ущерб составил 2000 рублей. Ведется проверка.
Дети из коррекционного центра села Чобручи впервые катались на лошадях.В конно-спортивном клубе «Аллюр» детей катали на коне по кличке Кекс. Он обучен к неопытным наездникам.
Похитил телефон у цветочницыИзрядно выпивший 43-летний рыбничанин 29 сентября вечером, около пяти, вышел из такси у цветочного магазина в Рыбнице, на улице Вальченко. Он попросил у 30-летней женщины-продавца мобильный телефон, чтобы позвонить....
Из Азии к нам идёт облако пыли, возможен «грязный дождь».По прогнозам синоптиков, это ожидается в среду. А уже к выходным качество воздуха улучшится.
5 октября вертикальный забег на ММЗ Соревнование посвящено 40-летию со дня первой плавки и выпуска первой стали. Участвовать могут все желающие с физподготовкой и допуском врача.Вертикальный забег - это бег вверх по лестницам.
Угледар взят Русской Армией!В Киеве заявили, что Угледар не имел стратегического значения.
Замглавы МИД РФ Рябков: Россия готовится к длительному противостоянию с США.По его словам, Москва посылает Вашингтону все необходимые предупреждения, чтобы он не недооценивал готовность России к противостоянию.
Байден уклонился от просьбы Зеленского использовать американские ракеты для ударов вглубь России, потому что опасность эскалации конфликта реальна.Такое мнение высказал писатель и колумнист The Washington Post Дэвид...
Ситуация по ОКИ – неустойчиво благополучнаяПо данным Минздрава, с23 по 29 сентября зарегистрировано 89 случаев острых кишечных инфекций, включая 54 среди детей. На прошлой неделе был 81 случай.У 22 заболевших выявлен возбудитель инфекции. Проведенное...
Союз журналистов Приднестровья объявляет набор в школу молодого журналиста!С октября 2024 года по май 2025 года школьники старших классов и молодёжь смогут познакомиться с основами профессии журналиста. Этот уникальный шанс предоставят мастера пера из...
Это студенты Приднестровского университета – участники нового проекта от Россотрудничества «Разговор на равных». Сегодня общаются с представителем Россотрудничества Артёмом Науменковым. Говорили об участии во всевозможных российских форумах...
Оперштаб. Беженцы из Украины. Информация на 30.09.2024 г.Всего с 24 февраля 2022 г.:– въехали в Приднестровье – порядка 306 190 иностранных граждан;– из них зарегистрировались в ПМР – 285 440;– воспользовались центрами для беженцев – порядка...
Вечером - на праздникСегодня в четыре вечера в сквере Борисовском состоится праздничная концертно-развлекательная программа с полевой кухней и горячим чаем. Для зрителей выступит муниципальный ансамбль песни и танца «Приетения».В это же время в...
Приднестровский госуниверситет отмечает день рождения. Главному вузу страны – 94.Администрация поводит итоги, суммирует достижения. А студенты – поздравляют альма-матер и празднуют.Чем живет сегодня ПГУ и с каким багажом подошёл к столь солидной дате?...
Время пить кофеВ первый день октября празднуется Международный день кофе.Осень – самое время для горячих и ароматных напитков. Таким является и кофе, крепкий и согревающий, - и у него есть собственный праздник.
Розовый октябрь в Приднестровье Весь месяц женщинам будут рассказывать о раке груди. Проведут осмотры по всем районам. А ещё будут лекции и Школа онкологических пациентов.Берегите себя!
Ситуация по ОКИ ухудшаетсяС 23 по 29 сентября зарегистрировано 89 случаев острых кишечных инфекций, включая 54 среди детей.На прошлой неделе был 81 случай.У 22 заболевших выявлен возбудитель инфекции, но бакпосев на холеру показал отрицательный результат.